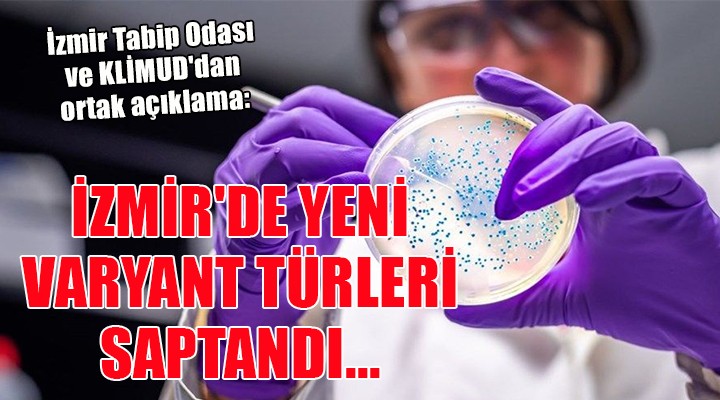

SONKALEİZMİR-İzmir Tabip Odası ve Klinik Mikrobiyoloji Uzmanlığı Derneği'nin (KLİMUD) ortak yazılı açıklaması şöyle:
"Yeni varyantların saptanması ve özelliklerinin araştırılabilmesi için nükleik asit dizi analizlerinin yaygınlaştırılması ve sonuçlarının açıkça paylaşılması gerekmektedir.
COVID-19’a neden olan virüsün (SARS-CoV-2) mutasyonlarının dünyada yayılmakta olduğu ve küresel bir tehdit oluşturduğu görülmektedir. Mutasyon, virüslerin çoğalması sırasında nükleik asit dizilerinde (genomunda) ortaya çıkan değişikliklerdir. İlk tanımlanan virüse göre farklı özellikler gösteren mutasyonlu virüslere VARYANT VİRÜS denmektedir.
SARS-CoV-2’nin toplumda hızlı yayılması ve çoğalması, virüste yeni mutasyonların ortaya çıkmasına, virüsün varlığını sürdürmesine yardım eden (örneğin, kolay yayılmasını, konak hücrelerine daha kolay girmesini, konağın bağışık yanıtlarından kaçabilmesini sağlayan) mutasyonların birikmesine yol açarak varyantların gelişmesine neden olmaktadır. Bu nedenlerle, hastalığın ortaya çıkmasını engelleyecek korunma stratejilerinin geliştirilmesi ve koruyucu önlemlerin hızlı bir şekilde uygulanması gereklidir. Bunun yapılabilmesi için toplumda var olan varyantların yakın izlemi, yeni varyantların saptanması ve elde edilen verilerin başta sağlık sunucuları olmak üzere toplumla hızlı paylaşımı kritik önem taşımaktadır.
Varyant virüsler, toplum sağlığı ve salgının seyri üzerine etkilerine dayanılarak gruplandırılmaktadır. Endişe verici varyantlar olarak şu anda alfa, beta, gamma ve delta varyantları tanımlanmaktadır. Ayrıca, gözlem altında tutulması gereken ve araştırma altında olan gruplarda çok sayıda varyant bulunmaktadır.
Ülkemizde şu anda başlıca mutasyonları saptayan farklı PCR kitleriyle varyantlar araştırılmaktadır. Bu kitlerin ve algoritmaların standardizasyonunun sağlanması ile sonuçlar daha iyi yorumlanabilecektir.
Sağlık Bakanı, Türkiye’de Delta varyantının baskın olduğunu bildirmiştir. Ancak İzmir’de, alfa, beta, gamma ve delta varyantlarındaki başlıca üç mutasyonu hedefleyen PCR kitleri ile yapılan analizlerde, üç mutasyonu da taşımayan suşlar saptanmaktadır. Ayrıca, bu mutasyonları farklı kombinasyonlarla taşıyan suşlar da bulunmaktadır. Bu suşların özelliklerinin anlaşılabilmesi için genom analizi (nükleik asit dizi analizi) yapılması gereklidir. Bu örneklerin bir kısmı Türkiye Halk Sağlığı Genel Müdürlüğü’ne (HSGM) ileri inceleme için yollanmakta, ancak sonuçları hakkında hekimlere ve topluma bir açıklama yapılmamaktadır. İller/bölgeler incelendiğinde enfeksiyon ve aşılama oranlarındaki farklara ek olarak varyantlarda da farklar oluşabileceği beklenmektedir. Varyant PCR testleri ile varyantların araştırılması yeterli değildir. Dizi analizi yapılacak örneklerin seçim kriterleri toplumdaki enfeksiyon ve hastalık özelliklerine göre belirlenmelidir. Bunlar yapılmadığı sürece mevcut varyantların ve yeni gelişecek olanların gözden kaçabileceği unutulmamalıdır.
Bu bağlamda, mikrobiyolojik olarak yapılması gerekenler aşağıda listelenmiştir.
1. Yeni veya ek riskler getiren mutasyonları taşıyan varyantların erken saptanabilmesi; nükleik asit dizi analizi çalışmalarının hızlanması, kapsayıcılığının arttırılması, yaygınlaştırılması ve örnek toplama kriterlerinin belirlenmesi ile mümkündür.
2. COVID-19 pozitif örneklerden temsiliyeti sağlayacak oranda rastgele seçilen örneklerin yanı sıra, belirli klinik ve epidemiyolojik özelliklerine göre toplanan örneklerde dizi analizi yapılması gereklidir. Aşıya ya da hastalığı geçirmiş olmalarına rağmen tekrar COVID-19 olanlar, farklı klinik gidiş gösteren veya uzamış ya da farklı bulaşma özellikleri olan vakalar/ vaka kümeleri, varyantın/varyantların risk oluşturduğu veya yeni bir varyantın bulunduğu ülkelerden gelenler gibi durumlar belirlenip örnekler toplanmalıdır.
3. HSGM tarafından yapılan dizi analizlerinin sonuçları düzenli olarak bir rapor halinde sağlık çalışanları ve toplumla paylaşılmalıdır.
4. Daha hızlı ve sağlıklı sonuçlar elde edilebilmesi için suşlar yerel laboratuvarlarda da değerlendirilebilmeli, dizi analizleri yaygınlaştırılmalı, bilgi, birikim ve alt yapı olanağı bulunan merkezler, üniversiteler desteklenmelidir.
5. Farklı suşların bulaşıcılık, bağışıklıktan kaçma, enfeksiyonunun klinik seyri gibi özellikleri incelenmelidir.
Eğer muhtemel yeni varyantlar mevcut ise, bunun çok hızlı şekilde paylaşılması ve bu bilgiden hareketle , bu varyantların özelliklerinin tespiti gerekir. Bu bilgiler, bundan sonraki süreçte pandeminin seyrinde rol oynayabilecek olan muhtemel yeni varyantlara karşı gerek toplumsal ve gerekse tıbbi anlamda pandeminin bilimsel gerçeklere dayanarak yönetilmesinde önemli veri kaynağı olacaktır.
Bu şekilde, salgın dinamiklerinin ve alınacak önlemlerin hızla değerlendirilebilmesi ve lokal gereksinime göre daha etkin mücadele mümkün olacaktır.
 |
 |
 |
 |
|||||
|
|
|||||||
 Küfür, hakaret içeren; dil, din, ırk ayrımı yapan; yasalara aykırı ifade ve beyanda bulunan ve tamamı büyük harflerle yazılan yorumlar yayınlanmayacaktır. Neleri kabul ediyorum: IP adresimin kaydedileceğini, adli makamlarca istenmesi durumunda ip adresimin yetkililerle paylaşılacağını, yazılan yorumların sorumluluğunun tarafıma ait olduğunu, yazımın, yetkililerce, fikrim sorulmaksızın yayından kaldırılabileceğini bu siteye girdiğim andan itibaren kabul etmiş sayılırım. |
| # | TAKIM | O | G | B | M | A | Y | AV | P |
|---|---|---|---|---|---|---|---|---|---|
| 1 | Galatasaray | 34 | 24 | 5 | 5 | 77 | 30 | 47 | 77 |
| 2 | Fenerbahçe | 34 | 21 | 11 | 2 | 77 | 37 | 40 | 74 |
| 3 | Trabzonspor | 34 | 20 | 9 | 5 | 61 | 39 | 22 | 69 |
| 4 | Beşiktaş | 34 | 17 | 9 | 8 | 59 | 40 | 19 | 60 |
| 5 | Rams Başakşehir | 34 | 16 | 9 | 9 | 58 | 35 | 23 | 57 |
| 6 | Göztepe | 34 | 14 | 13 | 7 | 42 | 32 | 10 | 55 |
| 7 | Samsunspor | 34 | 13 | 12 | 9 | 46 | 45 | 1 | 51 |
| 8 | Çaykur Rizespor | 34 | 10 | 11 | 13 | 46 | 52 | -6 | 41 |
| 9 | Tümosan Konyaspor | 34 | 10 | 10 | 14 | 43 | 50 | -7 | 40 |
| 10 | Kocaelispor | 34 | 9 | 10 | 15 | 26 | 38 | -12 | 37 |
| 11 | Corendon Alanyaspor | 34 | 7 | 16 | 11 | 41 | 41 | 0 | 37 |
| 12 | Gaziantep FK | 34 | 9 | 10 | 15 | 43 | 58 | -15 | 37 |
| 13 | Kasımpaşa | 34 | 8 | 11 | 15 | 33 | 49 | -16 | 35 |
| 14 | Natura Dünyası Gençlerbirliği | 34 | 9 | 7 | 18 | 36 | 47 | -11 | 34 |
| 15 | ikas Eyüpspor | 34 | 8 | 9 | 17 | 33 | 48 | -15 | 33 |
| 16 | Hesap.com Antalyaspor | 34 | 8 | 8 | 18 | 33 | 55 | -22 | 32 |
| 17 | Zecorner Kayserispor | 34 | 6 | 12 | 16 | 27 | 62 | -35 | 30 |
| 18 | Mısırlı.com.tr Fatih Karagümrük | 34 | 8 | 6 | 20 | 31 | 54 | -23 | 30 |
| 19 |

 Künye
Künye İletişim
İletişim Facebook
Facebook Twitter
Twitter RSS
RSS Sitene Ekle
Sitene Ekle Günün Haberleri
Günün Haberleri